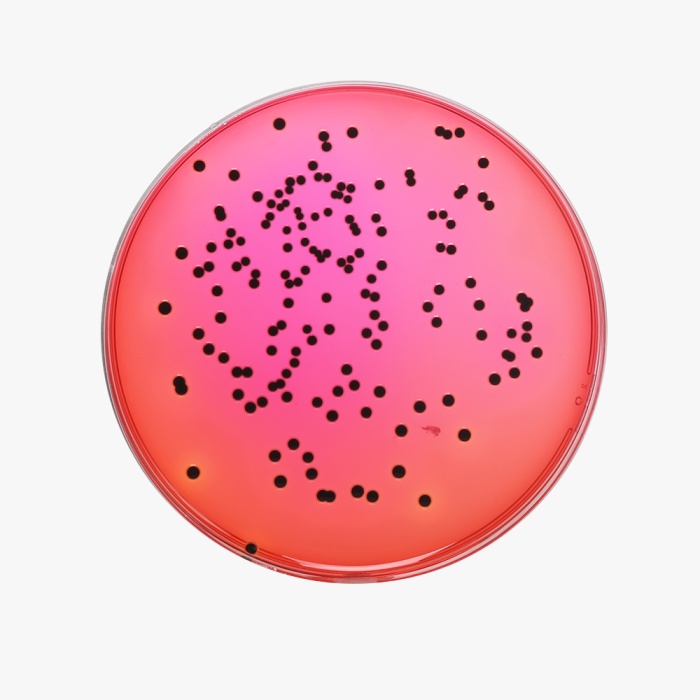

Your enquiry has been submitted
Xylose Lysine Deoxycholate Agar, Granulated (XLD Agar, Granulated)
Intended use
Recommended for the isolation and enumeration of Salmonella Typhi and other Salmonella species from clinical and non- clinical samples.
Composition
| Ingredients | g/L |
|---|---|
| Yeast extract | 3.000 |
| L-Lysine | 5.000 |
| Lactose | 7.500 |
| Sucrose | 7.500 |
| Xylose | 3.500 |
| Sodium chloride | 5.000 |
| Sodium deoxycholate | 2.500 |
| Sodium thiosulphate | 6.800 |
| Ferric ammonium citrate | 0.800 |
| Phenol red | 0.080 |
| Agar | 15.000 |
| Final pH (at 25°C) | 7.4±0.2 |
Formula adjusted, standardized to suit performance parameters
Directions
Suspend 56.68 grams in 1000 ml purified/distilled water. Heat with frequent agitation until the medium boils. DO NOT AUTOCLAVE OR OVERHEAT. Transfer immediately to a water bath at 45-50°C. Mix well and pour into sterile Petri plates. It is advisable not to prepare large volumes that will require prolonged heating, thereby producing precipitate. Note: Slight precipitation in the medium may occur, which is inherent property of the medium, and does not affect the performance of the medium.
Principle And Interpretation
XLD Agar has been recommended for the identification of Enterobacteriaceae (1) and for the microbiological testing. XLD Agar was formulated by Taylor (2-6) for the isolation and differentiation of enteric pathogens including Salmonella Typhi from other Salmonella species.of foods, water and dairy products (7,8,9,10). XLD Agar exhibits increased selectivity and sensitivity as compared to other plating media e.g. SS Agar (M108), EMB Agar (M022) and Bismuth Sulphite Agar (M027) (3,5,11, and 12,12,14,15). The media formulation does not allow the overgrowth of other organisms over Salmonella and Shigella (16). Samples suspected of containing enteric pathogens, along with other mixed flora, are initially enriched in Modified Semisolid RV Medium Base (M1482) (17).
The medium contains yeast extract, which provides nitrogen and vitamins required for growth. Though the sugars xylose, lactose and sucrose provide sources of fermentable carbohydrates, xylose is mainly incorporated into the medium since it is not fermented by Shigellae but practically by all enterics. This helps in the differentiation of Shigella species. Sodium chloride maintains the osmotic balance of the medium. Lysine is included to differentiate the Salmonella group from the non-pathogens. Salmonellae rapidly ferment xylose and exhaust the supply. Subsequently lysine is decarboxylate by the enzyme lysine decarboxylase to form amines with reversion to an alkaline pH that mimics the Shigella reaction. However, to prevent this reaction by lysine-positive coliforms, lactose and sucrose are added to produce acid in excess. Degradation of xylose, lactose and sucrose to acid causes phenol red indicator to change its colour to yellow. Bacteria that decarboxylate lysine to cadaverine can be recognized by the appearance of a red colouration around the colonies due to an increase in pH. These reactions can proceed simultaneously or successively, and this may cause the pH indicator to exhibit various shades of colour or it may change its colour from yellow to red on prolonged incubation. To add to the differentiating ability of the formulation, an H2S indicator system, consisting of sodium thiosulphate and ferric ammonium citrate, is included for the visualization of hydrogen sulphide produced, resulting in the formation of colonies with black centers. The non-pathogenic H2S producers do not decarboxylase lysine; therefore, the acid reaction produced by them prevents the blackening of the colonies (7). XLD Agar is both selective and differential medium. It utilizes sodium deoxycholate as the selective agent and therefore it is inhibitory to gram-positive microorganisms.
Type of specimen
Clinical samples - faeces, urine etc.; Food and dairy samples; Water samples.
Specimen Collection and Handling:
For clinical samples follow appropriate techniques for handling specimens as per established guidelines (18,19). For food and dairy samples, follow appropriate techniques for sample collection and processing as per guidelines (8,9). For water samples, follow appropriate techniques for sample collection, processing as per guidelines and local standards.(4) After use, contaminated materials must be sterilized by autoclaving before discarding.
Warning and Precautions :
In Vitro diagnostic Use. For professional use only. Read the label before opening the container. Wear protective gloves/protective clothing/eye protection/ face protection. Follow good microbiological lab practices while handling specimens and culture. Standard precautions as per established guidelines should be followed while handling clinical specimens. Safety guidelines may be referred in individual safety data sheets.
Limitations :
- Slight precipitation in the medium may occur, which is inheritant property of the medium,and does not affect the performance of the medium.
- This medium is general purpose medium and may not support the growth of fastidious organisms.
- Some Proteus strains may give red to yellow colouration with most colonies developing black centers, giving rise to false positive reactions.
- Non-enterics like Pseudomonas and Providencia may exhibit red colonies.
- S. Paratyphi A, S. Choleraesuis, S. Pullorum and S. Gallinarum may form red colonies without H2S, thus resembling Shigella species.
Performance and Evaluation
Performance of the medium is expected when used as per the direction on the label within the expiry period when stored at recommended temperature.
Quality Control
Appearance
Light yellow to pink colored granular medium
Gelling
Firm, comparable with 1.5% Agar gel
Colour and Clarity of prepared medium
Red coloured clear to slightly opalescent gel forms in Petri plates
Reaction
Reaction of 5.67% w/v aqueous solution at 25°C. pH : 7.4±0.2
pH
7.20-7.60
Cultural Response
Cultural response was observed after an incubation at 35-37°C for specified time. Recovery rate is considered as 100% for bacteria growth on Soyabean Casein Digest Agar.
| Organism | Inoculum (CFU) | Growth | Observed Lot value (CFU) | Recovery | Colour of Colony | Incubation period |
|---|---|---|---|---|---|---|
| Salmonella Typhimurium ATCC 14028 (00031*) | 50-100 | luxuriant | 25-100 | >=50% | red with black centres | 18-72 hrs |
| Salmonella Abony NCTC 6017 (00029*) | 50-100 | good-luxuriant | 25-100 | >=50% | red with black centres | 18-72 hrs |
| Escherichia coli ATCC 8739 (00012*) | 50-100 | fair | 10-30 | 20-30% | yellow | 18-72 hrs |
| Escherichia coli ATCC 25922 (00013*) | 50-100 | fair | 10-30 | 20-30% | yellow | 18-72 hrs |
| $ Proteus hauseri ATCC 13315 | 50-100 | good-luxuriant | 25-100 | >=50% | grey with black centres | 18 -72 hrs |
| Salmonella Paratyphi A ATCC 9150 | 50-100 | good-luxuriant | 25-100 | >=50% | red | 18-72 hrs |
| Salmonella Paratyphi B ATCC 8759 | 50-100 | good-luxuriant | 25-100 | >=50% | red with black centres | 18-72 hrs |
| Salmonella Enteritidis ATCC 13076 (00030*) | 50-100 | good-luxuriant | 25-100 | >=50% | red with black centres | 18-72 hrs |
| Salmonella Typhi ATCC 6539 | 50-100 | good-luxuriant | 25-100 | >=50% | red with black centres | 18-72 hrs |
| Shigella dysenteriae ATCC 13313 | 50-100 | good-luxuriant | 25-100 | >=50% | red | 18-72 hrs |
| Shigella flexneri ATCC 12022 (00126*) | 50-100 | fair-good | 15-40 | 30-40% | red | 18-72 hrs |
| Shigella sonnei ATCC 25931 | 50-100 | fair-good | 15-40 | 30-40% | red | 18-72 hrs |
| # Klebsiella aerogenes ATCC 13048 (00175*) | 50-100 | fair | 10-30 | 20-30% | yellow | 18-72 hrs |
| Enterobacter cloacae ATCC 13047 (00083*) | 50-100 | fair | 10-30 | 20-30% | yellow | 18-72 hrs |
| Staphylococcus aureus subsp. aureus ATCC 25923 (00034*) | >=104 | inhibited | 0 | 0% | >=72 hrs | |
| Staphylococcus aureus subsp. aureus ATCC 6538 (00032*) | >=104 | inhibited | 0 | 0% | >=72 hrs | |
| Enterococcus faecalis ATCC 29212 (00087*) | >=104 | inhibited | 0 | 0% | >=72 hrs |
Key: (*) Corresponding WDCM numbers.
# Formerly known as Enterobacter aerogenes $ Formerly known as Proteus vulgaris
Storage and Shelf Life
Store between 10-30°C in a tightly closed container and the prepared medium at 20-30°C. Use before expiry date on the label. On opening, product should be properly stored dry, after tightly capping the bottle in order to prevent lump formation due to the hygroscopic nature of the product. Improper storage of the product may lead to lump formation. Store in dry ventilated area protected from extremes of temperature and sources of ignition. Seal the container tightly after use. Product performance is best if used within stated expiry period.
Disposal
User must ensure safe disposal by autoclaving and/or incineration of used or unusable preparations of this product. Follow established laboratory procedures in disposing of infectious materials and material that comes into contact with clinical sample must be decontaminated and disposed of in accordance with current laboratory techniques (18,19).
Reference
- Chadwick P., Delisle G. H and Byer M., 1974, Can. J. Microbiol., 20, 1653-1664.
- Taylor W. L., 1965, Am. J. Clin. Pathol., 44:471-475.
- Taylor W. L. and Harris B., 1965, Am. J. Clin. Pathol., 44:476.
- Taylor W. L. and Harris B., 1967, Am. J. Clin. Pathol., 48:350.
- Taylor W. L. and Schelhart B., 1967, Am. J. Clin. Pathol., 48:356.
- Taylor W. L. and Schelhart B., 1968, Am. J. Clin. Pathol., 16:1387.
- Lipps WC, Braun-Howland EB, Baxter TE,eds. Standard methods for the Examination of Water and Wastewater, 24th ed. Washington DC:APHA Press; 2023.
- Salfinger Y., and Tortorello M.L. Fifth (Ed.), 2015, Compendium of Methods for the Microbiological Examination of Foods, 5th Ed., American Public Health Association, Washington, D.C.
- Wehr H. M. and Frank J. H., 2004, Standard Methods for the Microbiological Examination of Dairy Products, 17th Ed., APHA Inc., Washington, D.C.
- Williams H., (Ed.), 2005, Official Methods of Analysis of the Association of Official Analytical Chemists, 19th Ed., AOAC, Washington, D.C.
- Taylor W. L. and Schelhart B., 1969, Appl. Microbiol., 18.393-395.
- Dunn C. and Martin W. J., 1971, Appl. Microbiol., 22, 17-22.
- MacCarthy M. D., 1966, N. Z. J. Med. Lab. Technol., 20, 127-131.
- Rollender M. A., Beckford O., Belsky R. D and Kostroff B. 1969, Am. J. Clin. Pathol., 51, 284-286.
- Taylor W. L. and Schelhart B., 1969, Appl. Micro. 18, 1387-1392.
- Isenberg H. D., Kominos S., and Sigeal M., 1969, Appl Microbiol., 18, 656-659.
- Aspinall S. T., Hindle M. A. and Hutchinson D. N., 1992, Eur. J. Clin. Microbiol., Inf. Dis. 11, 936-939.
- Isenberg, H.D. Clinical Microbiology Procedures Handbook 2nd Edition.
- Jorgensen, J.H., Pfaller, M.A., Carroll, K.C., Funke, G., Landry, M.L., Richter, S.S and Warnock., D.W. (2015) Manual of Clinical Microbiology, 11th Edition. Vol. 1.
- FDA Bacteriological Analytical Manual, 2005, 18th Ed., AOAC, Washington, D.C.
- MacFaddin J. F., 1985, Media for Isolation-Cultivation-Identification-Maintenance of Medical Bacteria, Vol. 1, Williams and Wilkins, Baltimore.
| Product Name | Xylose Lysine Deoxycholate Agar, Granulated (XLD Agar, Granulated) |
|---|---|
| SKU | GM031 |
| Product Type | Granulated |
| Physical Form | Granular |
| Origin | Animal |
| Packaging type | HDPE |
| References | 1. Taylor W. L., 1965, Am. J. Clin. Pathol., 44:471-475. 2.Taylor W. L. and Harris B., 1965, Am. J. Clin. Pathol., 44:476. 3.Taylor W. L. and Harris B., 1967, Am. J. Clin. Pathol., 48:350. 4.Taylor W. L. and Schelhart B., 1967, Am. J. Clin. Pathol., 48:356. 5.Taylor W. L. and Schelhart B., 1968, Am. J. Clin. Pathol., 16:1387. 6.Taylor W. L. and Schelhart B., 1969, Appl. Microbiol., 18.393-395. 7.Chadwick P., Delisle G. H and Byer M., 1974, Can. J. Microbiol., 20, 1653-1664. 8.Salfinger Y., and Tortorello M.L. Fifth (Ed.), 2015, Compendium of Methods for the Microbiological Examination ofFoods, 5th Ed., American Public Health Association, Washington, D.C. 9.Baird R.B., Eaton A.D., and Rice E.W., (Eds.), 2015, Standard Methods for the Examination of Water andWastewater, 23rd ed., APHA, Washington, D.C. 10.Wehr H. M. and Frank J. H., 2004, Standard Methods for the Microbiological Examination of Dairy Products, 17th Ed.,APHA Inc., Washington, D.C. 11. Williams H., (Ed.), 2005, Official Methods of Analysis of the Association of Official Analytical Chemists, 19th Ed., AOAC,Washington, D.C.1 2.FDA Bacteriological Analytical Manual, 2005, 18th Ed., AOAC, Washington, D.C. 13.Dunn C. and Martin W. J., 1971, Appl. Microbiol., 22, 17-22.1 4.Rollender M. A., Beckford O., Belsky R. D and Kostroff B. 1969, Am. J. Clin. Pathol., 51, 284-286. 15.Taylor W. L. and Schelhart B., 1969, Appl. Micro. 18, 1387-1392. 16.MacCarthy M. D., 1966, N. Z. J. Med. Lab. Technol., 20, 127-131. 17.Isenberg H. D., Kominos S., and Sigeal M., 1969, Appl Microbiol., 18, 656-659.1 20.Isenberg, H.D. Clinical Microbiology Procedures Handbook. 2nd Edition.21. Jorgensen,J.H., Pfaller , M.A., Carroll, K.C., Funke, G., Landry, M.L., Richter, S.S and Warnock., D.W. (2015)Manual of Clinical Microbiology, 11th Edition. Vol. 1. |